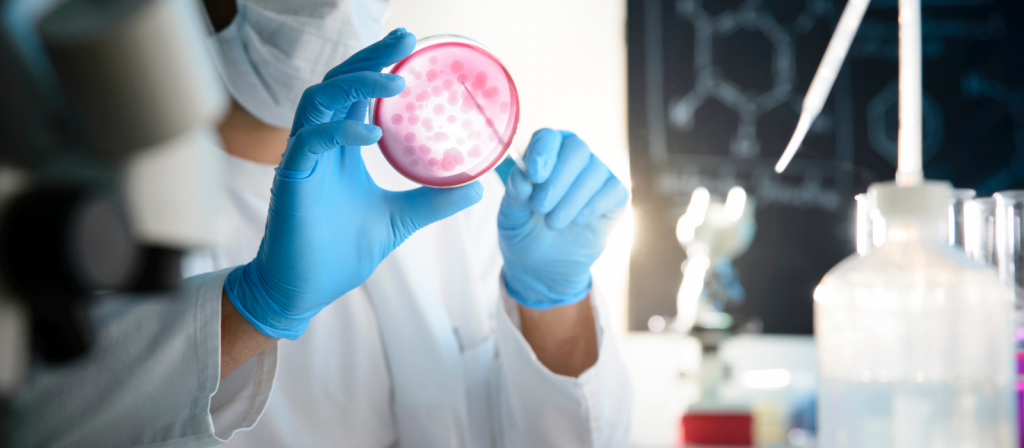

O que é o Caldo TSB?
Se você é estudante ou profissional da área de microbiologia, provavelmente já ouviu falar do caldo TSB. Esse meio de cultura é fundamental em laboratórios e pesquisa científica para o cultivo de microrganismos e realização de testes microbiológicos. Mas, afinal, o que é o caldo TSB? Qual a sua importância na microbiologia? Como ele é preparado e quais são suas principais aplicações? Neste artigo, vamos explorar tudo sobre esse importante meio de cultura utilizado na identificação e análise dos micro-organismos. Vamos lá!
O caldo é um meio de cultura utilizado em microbiologia para o cultivo e manutenção de microrganismos. Ele possui uma composição rica em nutrientes, proporcionando um ambiente propício ao crescimento das bactérias, fungos e leveduras.
A sigla TSB significa “Tryptic Soy Broth”, que traduzido para o português seria “Caldo Soja Triptona”. A triptona é uma proteína hidrolisada obtida a partir da caseína do leite e a soja fornece aminoácidos essenciais às bactérias. Essa combinação permite a utilização do caldo TSB para diferentes tipos de micro-organismos.
A importância do caldo TSB na microbiologia
A microbiologia é a área da biologia que estuda os microrganismos, como bactérias, fungos e vírus. Nesse contexto, o caldo TSB (Tryptic Soy Broth) tem grande importância na realização de testes microbiológicos.
O caldo é um meio de cultura líquido utilizado para cultivar uma ampla variedade de microrganismos em laboratórios. Ele fornece nutrientes essenciais para o crescimento bacteriano e pode ser usado tanto para culturas puras quanto mistas.
Além disso, o caldo também é útil na detecção de bactérias patogênicas em amostras clínicas ou ambientais. Isso porque ele permite a multiplicação das células bacterianas até números detectáveis por técnicas analíticas.
Como é preparado o caldo TSB?
O caldo TSB é um meio de cultura nutritivo que tem como base a triptona, extrato de levedura e cloreto de sódio. Ele é utilizado para o cultivo de diversos tipos de microrganismos em laboratórios microbiológicos.
Para preparar o caldo TSB , é necessário dissolver os componentes em água destilada ou desmineralizada, seguindo as proporções indicadas na literatura técnica. Geralmente, utiliza-se 30 gramas por litro (g/L) de triptona, 20 g/L de extrato de levedura e 5 g/L de cloreto de sódio.
Após a dissolução completa dos componentes na água, o pH do meio deve ser ajustado para cerca de 7.2 ±0.2 usando soluções ácidas ou alcalinas adequadas.
Quais são as suas principais aplicações?
O Caldo TSB é um meio de cultura líquido que possui diversas aplicações na microbiologia. Sua composição rica em nutrientes o torna ideal para o crescimento de uma ampla variedade de microrganismos.
Uma das principais aplicações do caldo TSB é no cultivo e manutenção de bactérias, leveduras e fungos para fins laboratoriais. Ele pode ser utilizado tanto para isolamento quanto para identificação destes microrganismos.
Além disso, o caldo TSB também é utilizado como meio de enriquecimento em amostras clínicas ou ambientais, auxiliando na recuperação dos microrganismos presentes nestas amostras.
Outra aplicação importante do caldo TSB é no teste de sensibilidade antimicrobiana. Este método consiste em avaliar a eficácia dos antibióticos contra os microrganismos presentes em uma determinada amostra, sendo que o Caldo TSB serve como meio para realizar este teste..
Perguntas frequentes sobre o Caldo TSB
O Caldo TSB é um meio de cultura utilizado em microbiologia para o crescimento de uma ampla variedade de microrganismos. No entanto, mesmo com sua popularidade, ainda existem algumas perguntas frequentes sobre esse meio. Aqui estão as respostas para seis das perguntas mais comuns sobre o caldo TSB:
1) Qual a composição do caldo TSB?
O Caldo TSB é uma mistura complexa composta por triptona (uma fonte de nitrogênio e aminoácidos), extrato de levedura (fonte adicional de nutrientes), glicose (fonte de carbono) e água destilada.
2) Como armazenar o caldo TSB?
O caldo TSB deve ser armazenado em temperatura ambiente, longe da luz solar direta e umidade excessiva. É importante verificar a data de validade antes do uso.
3) Qual a quantidade recomendada para o preparo do caldo TSB?
Uma dose típica é 30g/Litro.
O que dizem os especialistas sobre o Caldo TSB
O caldo TSB é amplamente utilizado na microbiologia, sendo um dos meios de cultivo mais populares para o crescimento e manutenção de diversos tipos de microrganismos. Mas o que dizem os especialistas sobre esse meio?
Segundo especialistas em microbiologia, o caldo TSB é altamente nutritivo e suporta uma ampla variedade de microrganismos, incluindo bactérias aeróbicas e anaeróbicas, leveduras e fungos. Além disso, sua composição química é bem definida, tornando-o ideal para estudos científicos.
Conclusão
Em suma, podemos concluir que o caldo TSB é um meio de cultura amplamente utilizado na microbiologia devido à sua capacidade de sustentar o crescimento bacteriano e fúngico. Sua preparação simples e versatilidade permitem uma variedade de aplicações em diferentes áreas da ciência.
Além disso, as propriedades do caldo TSB são bem estudadas pela comunidade científica, tornando-o um meio confiável para a realização de experimentos e testes microbiológicos.
Precisando de caldo TSB ? Entre em contato com nossa equipe!!
Não se esqueça de deixar aqui um comentário sobre a sua impressão ao ler o material.
AVISO DE DIREITOS AUTORAIS: Todo o material deste blog, sendo proibida toda e qualquer forma de plágio, cópia, reprodução ou qualquer outra forma de uso.
Qualquer dúvida técnica sobre os equipamentos contidos no portfólio SPLABOR, entre em contato com o Departamento de Vendas (sp@splabor.com.br)

A Splabor é uma empresa líder no ramo de fabricação de equipamentos para laboratório, especializada em oferecer uma ampla variedade de equipamentos para laboratórios, materiais e produtos para laboratório de alta qualidade.